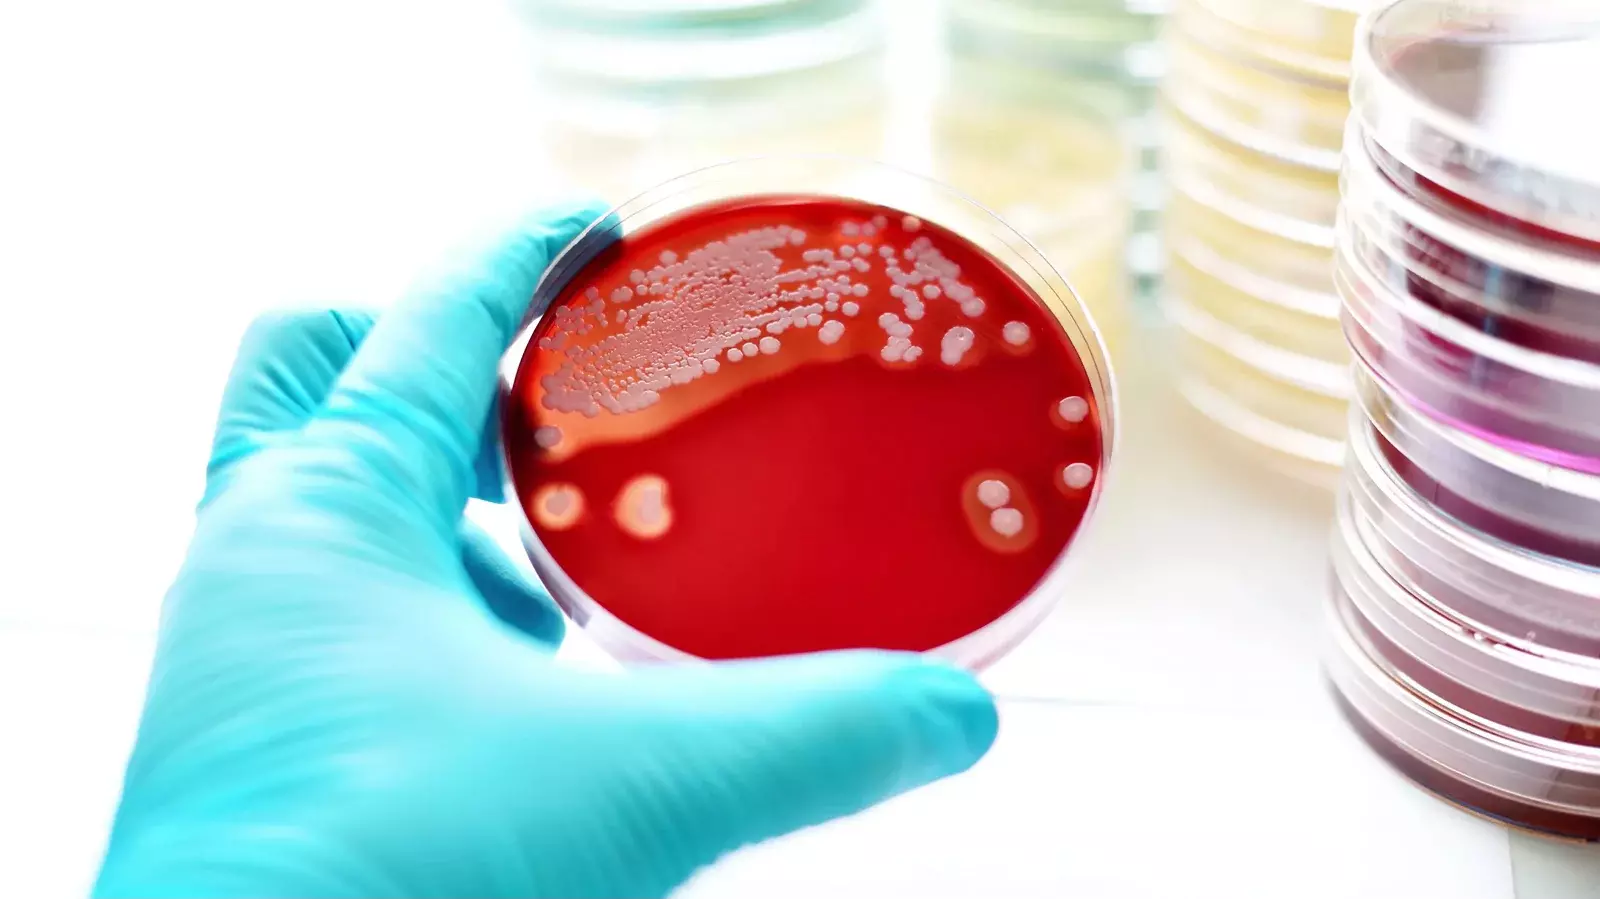

تعفن الدم أو بالإنجليزية Septicemia، والذي يُعرف أيضًا بـ تسمم الدم أو تجرثم الدم، كل هذه المصطلحات تشير إلى حالة تحدث عندما تصل البكتيريا أو الفيروسات أو الفطريات إلى مجرى الدم وتسبب العدوى.
عادةً ما يحدث تسمم الدم للأشخاص الذين يعانون من ضعف في جهاز المناعة؛ لذا فهو شائع الحدوث لدى كبار السن، ويمكن أن يكون خطيرًا جدًا ومهددًا للحياة.
البكتيريا المسببة لتسمم الدم لا تبدأ العدوى في مجرى الدم، ولكن تبدأ المشكلة كعدوى بكتيرية في مكان آخر من الجسم، على سبيل المثال: عدوى في المسالك البولية، أو الرئة، أو في مكان ما في الجهاز الهضمي، أو حتى خراج في الأسنان، وإذا لم تُعالج فإن العدوى قد تتفاقم وتنتشر إلى مجرى الدم، وتسبب حالة تسمم الدم.
تسمم الدم أو Septicemia هو ليس الإنتان أو الـ Sepsis على الرغم أن العديد من الأشخاص يستخدمون المصطلحين للتعبير عن الحالة نفسها، فعادةً ما يصف البعض حالة التعفن باسم إنتان الدم، ولكن نعرف الفرق بين الحالتين فيما يلي.
للتفريق بينهما بشكل مبسط، فإن تسمم الدم هو عدوى في مجرى الدم، في حين أن الإنتان هو استجابة الجسم لهذه العدوى، أي أن تسمم الدم يحدث أولًا فيستجيب الجسم بشكل شديد للعدوى وهذه الاستجابة تُعرف بالإنتان (إنتان الدم).
في أثناء الإنتان يبدأ الجهاز المناعي في مهاجمة أنسجة الجسم، ما يؤدي إلى تلف الأعضاء. قد تتكون أيضًا جلطات في الدم، مما يؤدي إلى انخفاض تدفق الدم إلى الأعضاء الداخلية، لذلك لا تحصل على العناصر الغذائية والأكسجين الذي تحتاجه.
في الحالات الشديدة، يسبب الإنتان انخفاضًا خطيرًا في ضغط الدم. يطلق الأطباء على هذه الحالة اسم "الصدمة الإنتانية"، وهي حالة قد تؤدي إلى فشل الأعضاء مثل: الرئتين والكليتين والكبد، بشكل سريع وهو ما قد يكون مميتًا.

تعفن الدم ليس هو نفسه سرطان الدم، فهما حالتان مختلفتان تمامًا، إذ يحدث سرطان الدم نتيجة طفرة في الجينات المرتبطة بالأعضاء المكوّنة لخلايا الدم مثل: نخاع العظم، ينتج عن هذه الطفرة إنتاج كريات دم بيضاء غير طبيعية تزاحم الخلايا السليمة، وتجعلها غير قادرة على القيام بوظائفها، ما ينتج عنه عدوى متكررة وأعراض فقر الدم وغيرها من العلامات. أما تعفن الدم فكما ذكرنا ينجم عن عدوى تنتقل إلى مجرى الدم.
يحدث تسمم الدم عادةً بسبب العدوى البكتيرية (وبشكل أقل شيوعًا بسبب العدوى الفطرية) في أجهزة الجسم المختلفة، عندما تنتقل البكتيريا من مكان العدوى إلى مجرى الدم.
تشتمل أنواع العدوى الشائعة التي قد ترتبط بتعفن الدم ما يلي:
قد يصيب الإنتان أي شخص في أي وقت، ولكن كبار السن هم أكثر عرضة للإصابة به خاصةً الأشخاص الذين تزيد أعمارهم عن 65 عامًا، وأولئك الذين يعانون من مشكلات صحية، إذ يكونون أكثر عرضة للإصابة بالإنتان بنسبة 13 مرة. وفقًا للإحصاءات فإن كبار السن يمثلون 65% من حالات الإنتان في المستشفيات، كما أن معدلات الوفيات أعلى أيضًا لدى المرضى الأكبر سنًا - فالإنتان هو السبب الرئيسي العاشر للوفاة بين الأشخاص الذين تبلغ أعمارهم 65 عامًا أو أكثر، وتزداد المعدلات مع تقدم العمر.
تظهر الأبحاث أيضًا أن المسنين هم أكثر عرضة للمضاعفات طويلة المدى لتسمم الدم مثل: الصدمة الإنتانية والبتر وفشل الأعضاء.
يُصاب كبار السن بتسمم الدم نتيجة عدوى وأكثرها شيوعًا، هي عدوى الجهاز التنفسي مثل: الالتهاب الرئوي، أو عدوى المسالك البولية
يكون كبار السن أكثر عرضة للإصابة بالإنتان بسبب:
كما ثبت أن الأمراض المزمنة مثل: السكري وأمراض الرئة والكلى والسكتة الدماغية والنوبات القلبية وارتفاع ضغط الدم تزيد بشكل كبير من خطر إصابة كبار السن بالإنتان.
تزداد فرص الإصابة بتسمم الدم في الحالات التالية:
بعض الأشخاص المصابين بتسمم الدم لا تظهر عليهم أي أعراض أو يعانون من حمى خفيفة فقط، ولكن تشمل أعراض تسمم الدم الأخرى ما يلي:
إذا كنت تعاني من الأعراض السابقة، فيجب عليك طلب المساعدة الطبية الفورية.
تظهر أعراض الإنتان نتيجة للانخفاض الشديد في ضغط الدم وبالتالي انخفاض تدفق الدم إلى الأعضاء، فيشعر المريض بما يلي:
الصدمة الإنتانية هي أخطر مراحل إنتان الدم، وتحدث عندما ينخفض ضغط الدم إلى مستوى خطير، فيتسبب في فشل الأعضاء، وقد يعاني المريض من:

يقيّم الطبيب التاريخ الصحي للمريض ويجري الفحص البدني لتحديد الجزء المشتبه به للعدوى. قد يوصي الطبيب بالفحوص التالية لتأكيد التشخيص:
إذا لم يكن مصدر العدوى واضحًا أو يمكن العثور عليه بسهولة، فيجب إجراء فحوص التصوير لتأكيد التشخيص ومنها:
يُعد العلاج المبكر لتجرثم الدم أمرًا بالغ الأهمية لمنعه من التحول إلى الإنتان أو الصدمة الإنتانية. إذا وصل المريض إلى المستشفى وهو يعاني من أعراض تسمم الدم، فسيوصي الطبيب بمضادات حيوية واسعة المدى عن طريق الوريد على الفور، حتى قبل أن يحدد مصدر العدوى، وذلك لأن الحالة يمكن أن تكون خطيرة جدًا، فحتى التأخير القصير في علاج العدوى قد يتسبب في انتشار العدوى وفشل الأعضاء.
يعتمد نوع المضاد الحيوي على نوع البكتيريا المسببة للعدوى. إذا كانت العدوى ناجمة عن فيروس أو فطر، فإن العلاج يشمل دواء مضاد للفيروسات أو مضاد للفطريات.
يمكن إعطاء المضادات الحيوية عن طريق الفم بمجرد السيطرة على مصدر العدوى وتحسن الأعراض بشكل ملحوظ.
في العموم يشمل علاج تعفن الدم البكتيري ما يلي:
عادةً ما يقضي المرضى المصابون بتسمم الدم حوالي أسبوع في المستشفى، وقد يقضون معظم هذا الوقت أو كله في وحدة العناية المركزة.
يتطلب علاج الإنتان البقاء في وحدة العناية المركزة بالمستشفى للسيطرة على العدوى والتحكم في ضغط الدم، والحفاظ على وظيفة أعضاء الجسم.
يشتمل علاج إنتان الدم على:
يؤدي التشخيص والعلاج الفوري للإنتان بالإضافة إلى الرعاية والمراقبة الدقيقة في وحدة العناية المركزة إلى زيادة فرص الشفاء.
في بعض الحالات قد يحتاج علاج تعفن الدم إلى التدخل الجراحي ومنها:
قد يكون من الضروري أيضًا إدخال أنبوب تصريف أو إزالة القسطرة المسببة للعدوى؛ لأنها لن تستجيب للعلاج بالمضادات الحيوية وحدها.
سيتلقى المريض معظم العلاجات في المستشفى من خلال الحقن الوريدية، وإذا تطورت الحالة للصدمة الإنتانية فإنه يحصل على حقن النورإبينفرين أو فازوبريسين لزيادة متوسط ضغط الدم.
ينجم تسمم الدم في معظم الحالات عن عدوى بكتيريا؛ لذا فإن العلاج الأول يكون من خلال المضادات الحيوية الوريدية، ثم يصف الطبيب المضادات الحيوية الفموية مثل:
الوقاية من العدوى هي أفضل طريقة لمنع تسمم الدم، وذلك من خلال الخطوات التالية:
وفي حال التعرض لعدوى بالفعل فمن المهم استشارة الطبيب فورًا لمعالجتها قبل أن تتفاقم.
إذا تُرك تعفن الدم دون علاج فإنه قد يتطور إلى صدمة إنتانية، والتي قد تسبب عديدًا من المشكلات في جميع أنحاء الجسم، ومنها:
وللأسف قد يعاني بعض المرضي، مما يُعرف بمتلازمة ما بعد الإنتان، وهي تأثيرات طويلة المدى يمكن أن تستمر لسنوات طويلة بعد الإصابة بالإنتان، وقد تشمل هذه التأثيرات:
في مجمل القول، فإن تعفن الدم هو حالة صحية طارئة تحتاج إلى التدخل الطبي العاجل، لأنها مهددة للحياة خاصةً لدى الرضع، ومن لديهم أمراض مزمنة، ولأن أعراضها قد تتطور بشكل سريع وتصل إلى مضاعفات خطيرة، فمن الضروري الاهتمام بمعالجة أي عدوى فور ظهورها وعدم إهمال أي عرض غير طبيعي.

مشاركة
هل لديك أي استفسار أو تعليق؟ نحن هنا لمساعدتك، أرسل لنا رسالة وسنرد عليك خلال ٢٤ ساعة.